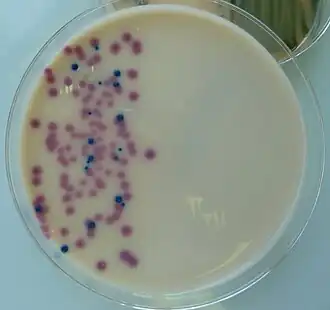
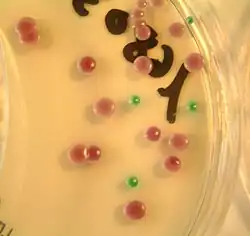
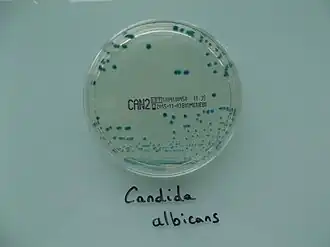

Milieu chromogène
Les milieux chromogènes sont très utilisés en microbiologie pour la mise en évidence d'activités enzymatiques par l'apparition d'une coloration spécifique. Leur introduction au laboratoire doit beaucoup à Alain Rambach.
La coupure par l'enzyme d'un substrat dit chromogène produit une molécule colorée, le chromophore. Pour les milieux chromogènes, le chromophore précipite au niveau de la colonie. Cette technique est différente de la mise en évidence d'activités par l'action des produits de la rédaction sur un indicateur de pH, rarement un indicateur rédox, du milieu.
Exemples
Le premier chromogène rencontré est l'ONPG (orthonitrophénylgalactoside) dont l'hydrolyse, par la β-galactosidase (ou ONPG-hydrolase) libère l'ONP (orthonitrophénol ou 2-nitrophénol) de coloration jaune. De très nombreuses enzymes sont mises en évidence par ce type de technique.
La diffusion de l'utilisation de chromogènes est devenue très importante par leur incorporation dans les milieux de culture : les colonies sont ainsi colorées par le ou les chromophore(s). Des colonies sont naturellement colorées ; la lecture est alors complexe car les couleurs peuvent s'additionner.
L'association de plusieurs chromogènes est souvent réalisée, par exemple la recherche de la β-glucuronidase et de la β-glucosidase dans les milieux destinées à l'analyse des urines en biologie médicale. D'autres enzymes sont recherchées pour les urines comme dans le milieu UTI (voir image ci-dessous)
Milieu URIDeux types de colonies sur URI. Les colonies rouges sont β-galactosidase +, coliformes probables. Les petites colonies bleues sont β-glucosidase + et sont des Enterococcus. Les grosses colonies bleues peuvent être des Klebsiella-Enterobacter-Serratia. ![]() |
Milieu CPSEMilieu adapté au diagnostic des infections urinaires, par la mise en évidence d'une activité β-glucuronidase, il permet une identification directe d'Escherichia coli responsable de 80 % des cystites en France (40 % à l’hôpital), il permet aussi la mise en évidence de l'activité β-glucosidase chez les entérocoques et certaines entérobactéries (Klebsiella, Enterobacter, Serratia et Citrobacter). Orientation possible vers Proteus grâce à la mise en évidence de l'activité TDA par addition d'une goutte de chlorure de fer III. La production d'indole est mise en évidence éventuellement par une goutte de réactif (Kovacs par exemple). Dans certaines compositions, du fer III dans le milieu visualise directement la TDA par une couleur brune autour des colonies TDA +. ![]() |
Milieu Chromagar pour les levuresAutre exemple avec le milieu Chromagar pour les levures. ![]() |
Milieu SALMMilieu sélectif des bactéries à Gram négatif qui permet la mise en évidence de Salmonella dans les selles grâce à la révélation d'une activité estérase que spécifique des salmonelles. |
CAN2Milieu sélectif des levures qui permet la mise en évidence de Candida albicans par la mise en évidence de l'activité hexosaminidase. ![]() |
Milieux existants
De nombreux milieux chromogènes existent. Malheureusement, les fabricants ne donnent pas toujours le nom des activités enzymatiques recherchées mais seulement les couleurs obtenues. Les tableaux ci-dessous (en préparation) tente une approche exhaustive qui devra être complétée.
| Enzymes recherchées | Taxons correspondants |
|---|---|
| α-Glucosidase | Staphylococcus aureus |
| β-Glucosidase | Listeria monocytogenes, Enterococcus-Klebsiella-Enterobacter, Serratia, Hafnia (KESH), Bacillus cereus, |
| α-Galactosidase | E. coli O157 |
| β-Galactosidase | Coliformes (1) |
| β-Glucuronidase | E. coli |
| β-D-Ribofuranosidase | |
| β-D-N-Acétylgalactosaminidinase | Candida albicans |
| Estérase | Salmonella |
| Phosphatidyl-myoinositol-1-phosphate phospholipase C | Probablement Listeria monocytogenes |
| β-Alanylaminopeptidase | Probablement Pseudomonas aeruginosa |
| β-Xylosidase | |
| Phosphatase |
Les milieux chromogéniques sont composés pour assurer la culture et une sélection, aussi importante que possible, des microorganismes cibles.
| Nom du milieu | Enzymes recherchées | Utilisation |
|---|---|---|
| Uriselect Biorad | β-Galactosidase et β-glucuronidase | Analyse des urines en biologie médicale |
| CPSE Biomérieux | β-Glucosidase et β-glucuronidase | Analyse des urines en biologie médicale |
| UTI | β-Glucosidase et β-galactosidase | Analyse des urines en biologie médicale |
| Chrom Id VRE | β-Glucosidase | Recherche des Enterococcus résistants aux glycopeptides |
| HiChrom rapid Enterococci Agar | α-Glucosidase, β-glucosidase, β-galactosidase | Recherche d'Enterococcus |
| Chrom Id VRE E. coli O157 | β-Glucosidase, β-galactosidase | Recherche d'E. coli O157 |
| ALOA (Listeria monocytogenes) | β-Glucosidase | Dénombrement des Listeria monocytogenes |
| Nombreux milieux | β-Glucuronidase | Dénombrement d'E. coli (microbiologie alimentaire) |
| Candiselect Biorad | β-D-N-Acétylgalactosaminidinase | Recherche de Candida albicans |
| CAN2 Biomérieux ou ChromId Candida | β-D-N-Acétylgalactosaminidinase et phosphatase | Recherche de Candida albicans |
| HiChrom OGYE | β-Xylosidase | |
| Bacillus cereus HiCrome Agar | β-Glucosidase | Dénombrement de Bacillus cereus |
| SAIDE Biomérieux | α-Glucosidase probablement | Staphylococcus aureus |
| MRSA [Bio-Rad Laboratories (MRSASelect), Becton Dickinson (CHROMagar MRSA) bioMérieux (chromID MRSA)] | α-Glucosidase probablement | Recherche des SARM |
| ESBL Biomérieux
[BBL CHROMagar ESBL] |
Probablement β-glucosidase et β-glucuronidase (comme pour les urines) | Recherche des entérobactéries productrices de BLSE |
| STRB Biomérieux
[chromID Strepto B…] |
Recherche des streptocoques du groupe B |
Nature des chromophores
Les chromogènes et les chromophores ne doivent pas être toxiques pour les bactéries recherchées, à la concentration utilisée.
Un exemple de chromophore pour la β-glucuronidase :

Mais d'autres substrats sont possibles pour cette enzyme probablement en raison des droits de brevets.
![]() |
![]() |
![]() * le 5-bromo-4-chloro-3-indolyl-β-glucuronide ; * le 5-bromo-6-chloro-3-indolyl-β-glucuronide ; * le 6-chloro-3-indolyl-β-glucuronide. |
| Formule à déterminer, probablement protégée par le secret industriel, ex. : aldol-β-glucuronide | Formule à déterminer
Cyclohexènoesculetine-β-glucuronide |
Bibliographie
- Catherine de Beaumont, Intérêt des milieux chromogènes en microbiologie, 2006.
- Jean-Noël Joffin et Guy Leyral, Dictionnaire des techniques, Microbiologie technique, CRDP d'Aquitaine (voir www.reseau-canope.fr/).
- Alain Rambach, Opéron no 102, article de l'initiateur des milieux chromogènes.
Notes et références
- Portail de la biochimie
- Portail de la microbiologie